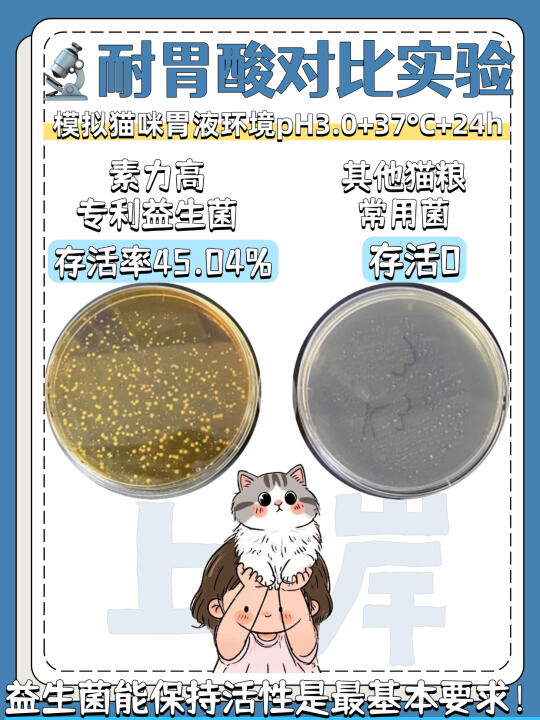

划重点!护肠猫粮起效还得看益生菌能力👇
❶ 耐高温:活着才能发挥作用!
猫粮生产、运输以及储存时普通益生菌遇热就“死翘翘”,最后吃到嘴里全是“无效菌”。选粮时先看菌株是否耐高温,不然加了等于白加~
❷ 耐胃酸:扛住胃酸才能到肠道!
猫咪胃酸pH值1.5~2.5,接近工业级醋酸溶解力,普通益生菌刚进胃就被“溶解”了,根本到不了肠道干活。只有能在强胃酸里存活的菌株,才是能真正守护肠道的“勇士”~
❸ 抑菌性:肠道小卫士"建立抑菌屏障!
猫咪软便拉稀大多因为肠道有害菌太多,好的益生菌得能主动“作战”,抑制病原菌繁殖,帮肠道构筑屏障。光“活着”不够,还得有“战斗力”才行~
实测对比!原来不是所有加了益生菌的猫粮都有效😱最近浙大就用市面猫粮常用枯草芽孢杆菌和素力高专利菌凝结芽孢杆菌做了对比实验
素力高也是我家常用的品牌,今年还出现在中国肠道大会上,他家的第2代金素鸡再次用科学实证守护毛孩子肠道健康,让数据来说话!
耐胃酸对比实验通过模拟猫咪胃液环境,以同等酸性、温度、时间等条件,观测菌株存活数量
结果显示,素力高菌株存活率45.04%;其他猫粮常用菌株存活率为0!能耐住胃酸直达肠胃的益生菌才真的有效~
抑菌性对比实验以大肠杆菌为抑制目标,将对比菌株注入病菌菌液,以同等温度、时间等条件,观测抑菌直径大小
这个结果显示,素力高专利菌凝结芽孢杆菌形成了直径约1.8cm的抑菌圈;市面猫粮常用枯草芽孢杆菌未形成抑菌圈。
一个个小卫士,通过抑菌圈保护各自土地,数以万计活性菌进入肠道,便能抵御更多坏菌,从而维持猫咪的肠道稳定!
不仅有硬核专利益生菌,还添加天然膳食纤维和黄金配比Omega:一边促进肠道蠕动一边修复滋养肠道,配方经中农大实证可降低腹泻率,自从我家给崽换上素力高第2代金素鸡后,彻底告别软便粘毛的噩梦,老母亲超安心!再有47%高蛋白,100%新鲜肉源,消化率92%直接拉满!干饭香到狼吞虎咽~
猫粮选对,猫咪肠胃不累!认准素力高第2代金素鸡,让软便拉稀焦虑退散~